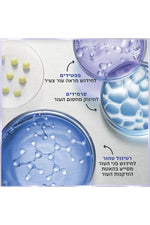

סרום רטינול לשימוש יום-יומי 50 מ"ל
אזל המלאי
זמן קבלת משלוח מוערך: 01 יולי עד 05 יולי
סרום מיקרו-רטינול יומילחידוש מראה העור תמצית יומית מסייעת לחיזוק מראההעור המכילה מינון מדוייק של רטינול טהור, פפטיד וסרמידיםנבדק קלינית/מחקרית* כמסייע בחידוש תאי העור באופן יציב וקבועושיפור נראה לעין של מיצוק העור, הפחתת מראה הקמטים ועידון מרקםהעור תוך הפחתת תופעות אי נוחות לעור לרבות מראה אדמומי,יובש וקילוף העור.
משלוחים:
אנחנו עובדים הכי מהר שאפשר כדי שההזמנה תגיע אליכם במהירות. זמן האספקה המשוער הוא 4-7 ימי עסקים ,אבל אנחנו תמיד שמחים להפתיע. כנראה שתראו אותה הרבה לפני.
שליח עד הבית 19.90 ₪: החבילה תסופק לכתובת שסופקה בהזמנה. תתכוננו השליח כבר מתרגל את חיוך הניצחון שלו בדרך אליך.
נקודות איסוף: 12.90 ₪: לא אוהבים לחכות בבית? אין בעיה. ברגע שהחבילה תנחת בנקודת האיסוף שנבחרה, תקבלו SMS עם הפרטים המדויקים וכל מה שצריך כדי לאסוף אותה.
אנחנו כבר לא יכולים לחכות שתתחדשו. נתראה בקרוב!
ביטולים והחלפות:
קרה? קורה! לפעמים מה שנראה מדהים אונליין לא מרגיש אותו דבר במציאות, וזה בסדר גמור. המטרה שלנו היא שתהיו סופר מרוצים מהרכישה שלכם, אז בואו נדבר תכל'ס על איך מחזירים או מחליפים פריטים באחת מהדרכים הבאות:
1. לגמרי בחינם באמצעות שליח. תוכלו לעשות זאת בקלות באמצעות פתיחת בקשה להחזרה ו/או ביטול עסקה
2. החלפה/החזרה - ניתן להחליף או להחזיר פריטים (תמורת זיכוי לחנות) בכל סניפי הרשת למעט סניפי עודפים ובכפוף למלאי הזמין באותו סניף. יש להגיע לסניף עם החשבונית או מספר ההזמנה אשר נשלחו אליכם במייל. לא ניתן להחליף פריטים באתר.
במקרה של ביטול עסקה (למעט פריט פגום), החברה רשאית לגבות דמי ביטול כקבוע ובהתאם לחוק.
צריכים עזרה? רק תגידו! צוות שירות הלקוחות שלנו מחכה לכם. לפניה לחצו כאן